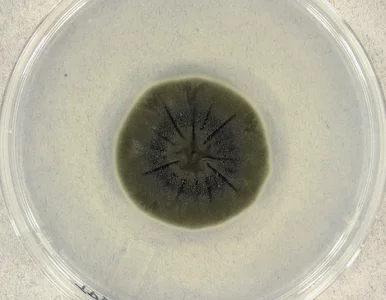
Miniatura: Grzyb z Czarnobyla żywi się śmiertelnym...

-
„Wielkie Kolędowanie” pierwszy raz na żywo. Kiedy emisja?TelewizjaGwiazdyRozrywka Wprost

-
Tak Polacy chcą podreperować budżet przed świętami. Eksperci odradzają

-
Duża zmiana w europejskim mieście. Turyści zapłacą tu więcej za noclegi

-
Nauczyciel wyzywał ukraińskich uczniów. Po zajęciach zostali pobici

-
Złowił rybę, która pobiła własny rekord. „Wieczór, którego nigdy nie zapomnę”

-
Tu nie stawiaj telewizora! Ekspertka wskazuje 4 najgorsze miejsca na telewizor
Magda Grefkowicz
-
Ekspresowy quiz ortograficzny. Wraca koszmar szkolnych dyktand!
Quiz
-
Plotki o Krupie i polityku PiS nie ustają. Modelka zabrała głosGwiazdyRozrywka Wprost

-
Złe wieści dla Karola Nawrockiego. Polacy ocenili jego niezależność polityczną

-
Prof. Banach: W profilaktyce wiele dobrego się zdarzyło w ostatnim czasie
Wideo
-
Moja babcia robiła to przed świętami. Jeden trik usuwa zapach smażenia w kilka minut
Ewa Jagalska
-
Rewolucja w polskiej szkole? Decyzja w rękach Nowackiej. Ten temat wywołał burzę

-
Grzyb z Czarnobyla żywi się śmiertelnym promieniowaniem. To przepustka do podróży w kosmos?
-
Nowa opcja dla oszczędzających już niebawem. Rząd zdradził plany

-
Putin odrzuca plan pokojowy i grozi Europie wojną. „Sytuacja może bardzo szybko eskalować”

-
W doniczce pojawiła się pleśń? To, co zrobisz teraz, uratuje rośliny
Ewa Jagalska
-
Tusk zacznie walczyć z Kościołem? „Dojrzewa do tego pomysłu”
Jan Wróbel
-
Eksperci nie mają wątpliwości. To ryba idealna dla dzieci i seniorów: wzmacnia mózg, serce i kości

-
Prognoza pogody na Święta Bożego Narodzenia. Meteorolodzy odsłaniają karty. Nowe modele

-
Finał „ŚOPW” wywołał burzę. Widzowie nie mieli litości dla uczestnikówTelewizjaRozrywka Wprost

-
Wsyp szczyptę soli do tealighta. To, co stanie się po minucie, zaskoczy każdego!
Magda Grefkowicz